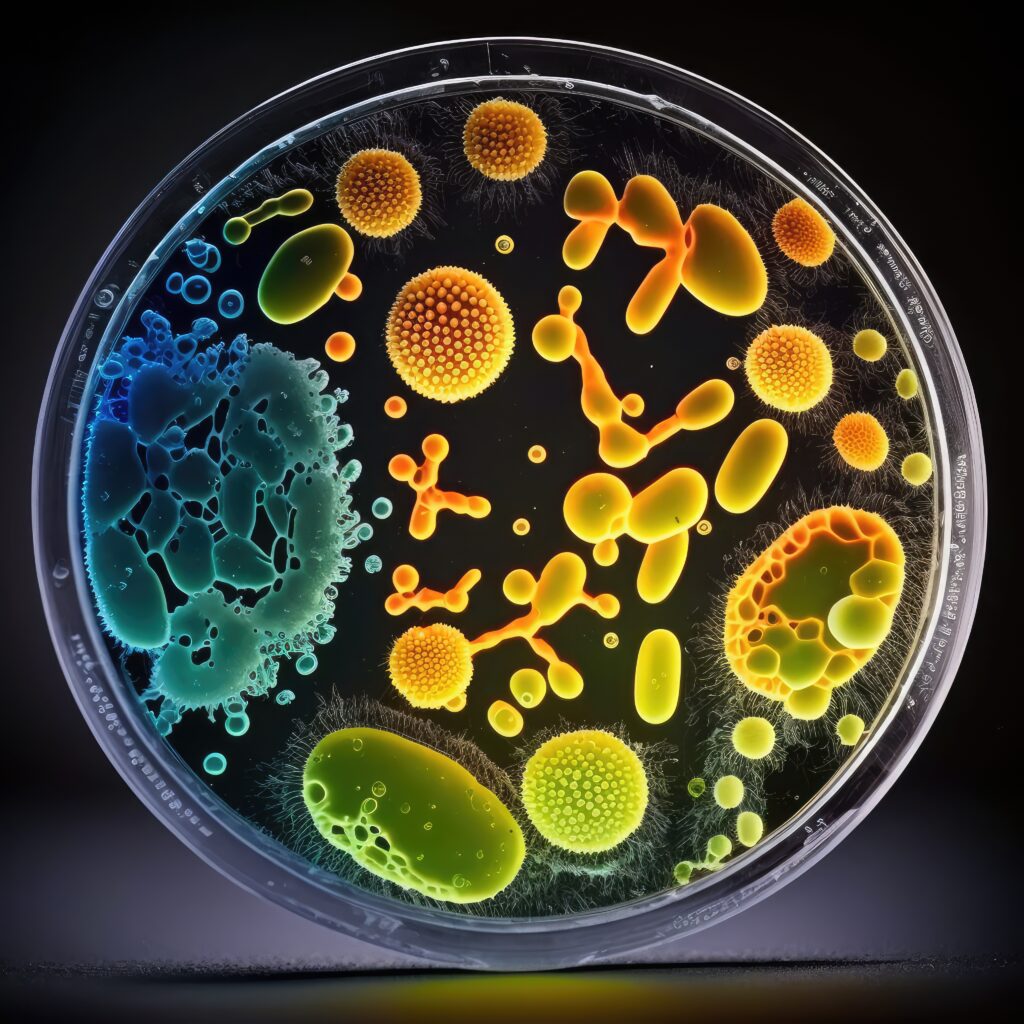

Krankenhaushygienische Beratung
Kompetente Informationen für Klinikleitungen zu Aus- und Bewertungen von Kennzahlen in Hygiene und Infektiologie, fachkundige Beratung der Ärzte in allen Fragen der Antibiotikatherapie und qualifizierte Unterstützung der Hygienefachkräfte bei der Durchführung ihrer Arbeit

Antibiotikamanagement
Multiresistente Erreger sind kein Schicksal, sondern häufig die Konsequenz einer falschen Antibiotikastrategie

Infektionsprävention
Infektionen und Übertragungen werden durch korrektes Verhalten und sinnvolle Prozesse vermieden
Mikrobiologische Surveillance
Keim- und Resistenzstatistiken gehören zum Pflichtprogramm der Labore. Eine gute Aufbereitung der Daten kann wichtige Informationen zu Hygiene und Antibiotikaeinsatz liefern. Wenn man die Daten des Antibiotikaverbrauchs berücksichtigt und die tatsächliche Therapie bei ausgewählten Infektionen (z.B. S.aureus-Bakteriämie) auswertet, dann erhält man ein sehr informatives Gesamtpaket.
Wir übernehmen das gerne für Sie!
Einsatz von Antibiotika
Antibiotika sind eine der großen Errungenschaften der modernen Medizin. Ihr Einsatz geht jedoch mit dem Risiko des Kollateralschadens, der Schädigung des Mikrobiomes und der Selektion von multiresistenten Keimen einher. Gerne beraten wir Sie im Einzelfall beim einzelnen Patienten, aber auch bei der Auswahl geeigneter Antibiotika für die Hausliste und der Festlegung geeigneter Antibiotikastrategien.


Bauhygiene
Krankenhausgebäude werden um- oder neugebaut. Dieses so zu gestalten, dass hinterher Abläufe hygienegerecht funktionieren, soll gemäß der Bayerischen Medizinhygieneverordnung durch ein Bauhygienegutachten sichergestellt werden. In der Praxis empfiehlt es sich, Krankenhaushygieniker von an Anfang an in die Planungen mit einzubinden. Wir unterstützen Sie hier gerne.
Trinkwasserhygiene
Mängel im Betrieb oder bei der Ausführung von Trinkwasserinstallationen können zur Bildung von Biofilm in den Leitungen führen. Aus diesem können Keime freigesetzt werden, die vulnerable Personen – also Patienten – gefährden. Deshalb fordert die Trinkwasserverordnung die Einhaltung der allgemein anerkannten Regeln der Technik. Gerade in Krankenhäusern mit einer älteren Gebäudesubstanz stellt das eine Herausforderung dar. Aber auch bei Neu- und Umbauten sind die Anforderungen höher, als es Planer und Bauherren häufig bewusst ist: Nicht jeder Wasserhahn ist für den Einsatz im Krankenhaus geeignet, aber auch nicht jede Maßnahme die Mühen wert.

Haben wir Ihr Interesse geweckt?
In einem persönlichen Gespräch lassen wir Ihnen gerne weitere Informationen zukommen.
